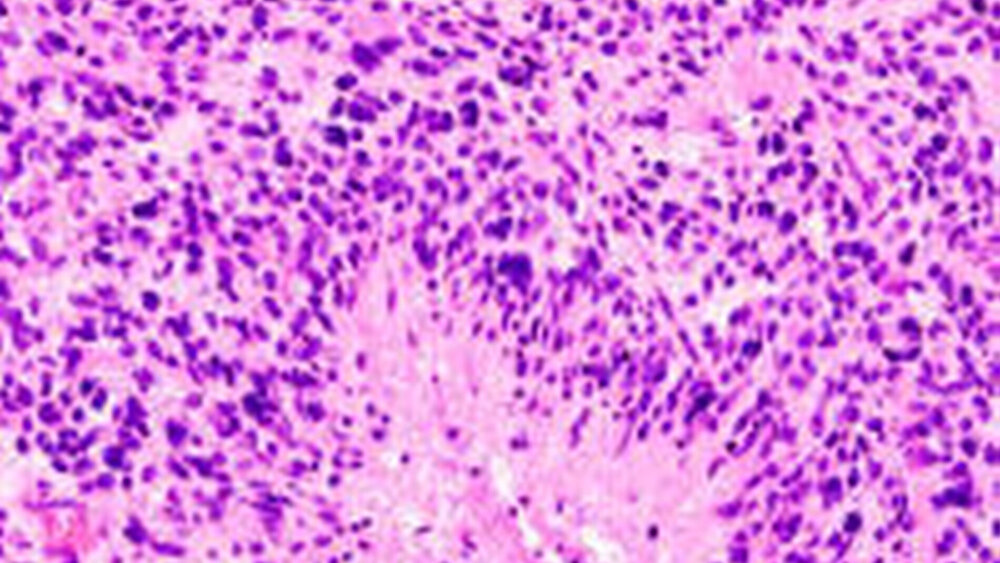

Hirntumore
Maligne Veränderungen des Gehirns und des Rückenmarks sind im Vergleich zum Lungen- oder Mammakarzinom selten. Sie machen nur etwa zwei Prozent aller Krebserkrankungen aus, wobei jährlich rund 8 000 Menschen in Deutschland neu an einem Hirntumor erkranken. Männer sind insgesamt etwas häufiger betroffen als Frauen, allerdings treten einzelne Tumore, wie die Meningeome, bei Frauen häufiger als bei Männern auf.
Das Manifestationsalter zeigt zwei Häufigkeitsgipfel. Wenngleich Tumore in praktisch jedem Lebensalter auftreten können, bilden sie sich doch überproportional oft im Kindesalter. Ein zweiter Altersgipfel liegt zwischen dem 50. und 70. Lebensjahr, wobei sich die Tumorarten allerdings unterscheiden. Bei Kindern finden sich vor allem gutartige Gliome und maligne verlaufende Medullablastome. Bei älteren Menschen stehen dagegen bösartige Gliome sowie gutartige Meningeome im Vordergrund, wie die Deutsche Krebsgesellschaft informiert.
Unterschieden wird nach primären und sekundären Tumoren. Der Begriff primärer Hirntumor bezeichnet Geschwülste, die direkt vom Gehirn oder den umgebenden Hirnhäuten ausgehen. Sekundäre Hirntumore sind dagegen Tochtergeschwülste anderer Krebserkrankungen, die sich als Metastasen im Gehirn absiedeln und dort heranwachsen.
Die Ursachen ihrer Entstehung sind bislang noch unklar. Bei einigen seltenen Hirntumoren ist eine genetische Komponente bekannt, bei der Mehrzahl der Veränderungen aber liegt die Ursache im Dunkeln. Auch kennt man anders als beim Lungenoder Mammakarzinom keine Risikofaktoren wie Rauchen oder fettreiche Ernährung, die die Krebsentstehung triggern. Einzig bei direkter radioaktiver Bestrahlung, wie sie bei einer Leukämiebehandlung notwendig werden kann, ist ein Zusammenhang gesichert. Immer wieder diskutiert wird ferner, ob nicht auch elektromagnetische Strahlung und insbesondere das häufige Nutzen von Mobiltelefonen die Gefahr der Entwicklung eines Hirntumors erhöhen. Aktuelle Untersuchungen haben solche Zusammenhänge aber bislang nicht sichern können.
Klinische Symptome
Hirntumore können sich, je nachdem wo sie lokalisiert sind und von welchen Strukturen sie ausgehen, mit unterschiedlichen Beschwerden bemerkbar machen. Erste Symptome sind nach Angaben der Krebsgesellschaft oft keineswegs, wie häufig angenommen Kopfschmerzen. Vielmehr kommt es oft zunächst zu neurologischen Ausfallerscheinungen, zu Lähmungen und Gefühlsstörungen, zu Sprach- und Sprechstörungen, zu epileptischen Anfällen und Persönlichkeitsveränderungen. Auch Übelkeit und Erbrechen können auftreten, Schwindel und schließlich auch Kopfschmerzen.
Ihren Ursprung können die malignen Veränderungen von ganz unterschiedlichen Zellen im Gehirn nehmen. Sie werden anhand dieser Ursprungszellen klassifiziert. Am häufigsten geht das krankhafte Wachstum mit rund 60 Prozent der Prozesse von den Gliazellen aus und es kommt zur Bildung derGliome. Das Gehirn enthält rund zehn- bis 50-mal mehr Gliazellen als Neurone. Ihnen wird vor allem eine Stützfunktion zugesprochen sowie die elektrische Isolation der Nervenzellen. Neuere Befunde deuten ferner an, dass Gliazellen auch maßgeblich am Stoff- und Flüssigkeitstransport im Gehirn beteiligt sind und möglicherweise sogar an der Informationsverarbeitung.
Die Gliazellen gliedern sich in Astrozyten, auch Astroglia genannt, welche die Mehrheit der Gliazellen ausmachen sowie in die Oligodendroglia. Entsprechend werden die Gliome unterteilt inAstrozytome, Oligodendrogliome, und in Mischgliome, die so genanntenOligoastrozytome.
Gehen die Tumore von den Hirnhäuten aus, so spricht man vonMeningeomen. Sie stellen die zweithäufigste Gruppe der Gehirntumore dar. Maligne Prozesse, die auf Neuronen basieren, werden alsNeurinomebezeichnet, solche die sich von Schwannschen Zellen, den Hüllzellen der Neurone ableiten, bezeichnet man alsSchwannome. Im Kindesalter spielt ferner das vom Kleinhirn ausgehendeMedullablastomeine große Rolle.
WHO-Grade zur Prognoseabschätzung
Zur Prognoseabschätzung wurden ferner durch die Weltgesundheitsorganisation vier Tumor-Grade formuliert:
Grad Ibezeichnet ein gutartiges, langsames Tumorwachstum mit sehr guter Prognose des Patienten. WHO-Grad IIklassifiziert ebenfalls eine gutartige Geschwulst jedoch mit erhöhter Neigung zur Rezidivbildung und möglichem Übergang in einen malignen Tumor. Mit WHO-Grad IIIwerden bösartige Tumore bezeichnet, die nach der Operation einer Strahlen- und/ oder Chemotherapie bedürfen, und WHOGrad IVbeschreibt hochmaligne Prozesse mit raschem Wachstum und schlechter Prognose des Patienten.
Die Einteilung hat therapeutische Bedeutung. So lassen sich Tumore mit Grad I und II in aller Regel operativ entfernen, die Patienten gelten nach der Operation als geheilt. Anders bei Grad III und IV, bei denen stets nach der Operation eine weitere Behandlung notwendig ist, um potentiell im Gehirn verbliebene bösartige Zellen möglichst abzutöten.
Selten Metastasierung
Die Gefahr, dass diese entarteten Zellen zurückbleiben, ist bei Hirntumoren infolge einer Besonderheit der Zellen höher noch als bei anderen Krebserkrankungen. Denn viele Tumore bilden Zellen, die aus der Geschwulst ins benachbarte Gewebe auswandern. Dort können sie zu neuen Tumoren auswachsen, was die hohe Rezidivneigung mancher Hirntumore erklärt.
Andererseits bilden Hirntumore seltener als viele andere Krebsformen Tochtergeschwülste in anderen Organssystemen, ihre Neigung zur Metastasierung ist – abgesehen von aggressiven Formen wie dem Glioblastom oder dem Medullablastom – allgemein gering.
Astrozytome und Glioblastome
Bei den Astrozytomen werden zwei Gruppen unterschieden, und zwar zum einen bösartige Geschwülste, die diffus ins Hirngewebe einwachsen, zum andere Tumore mit besser abgegrenztem Wachstum. Vertreter der diffus wachsenden Strukturen sind das diffuse Astrozytom mit WHO-Grad II, das anaplastische Astrozytom mit WHOGrad III und das gefürchtete Glioblastom mit WHO-Grad IV. Hauptvertreter des besser abgegrenzten Tumortyps ist das so genannte pilozystische Astrozytom mit WHOGrad I, das in aller Regel durch eine operative Entfernung geheilt werden kann.
Schwieriger ist die Situation beim diffusen Astrozytom, das zumeist ohne scharfe Grenze zum gesunden Gewebe in der weißen Substanz des Großhirns wächst. Der Tumor tritt überdurchschnittlich häufig bei jungen Erwachsenen auf und kann in ein anaplastisches Astrozytom oder ein Glioblastom übergehen.
Bei der Operation wird eine möglichst weitgehende Resektion angestrebt, wobei jedoch die völlige Entfernung der malignen Strukturen kaum möglich ist. In der Regel schließt sich deshalb eine Radiotherapie an, bei weiterem Wachstum unter Umständen auch eine Chemotherapie.
Zu den bösartigen Tumoren zählen das anaplastische Astrozytom, das sich ebenfalls oft schon im jungen Erwachsenenalter bildet und das Glioblastom als bösartigster Hirntumor. Er tritt vorwiegend bei Erwachsenen auf und ist meist im Großhirn lokalisiert. Trotz intensivster Therapie mit Operation, Strahlenbehandlung und Chemotherapie ist die Prognose schlecht, allerdings wurden in Einzelfällen Überlebenszeiten von bis zu drei Jahren beschrieben.
Meningeome
Meningeome entstehen aus den Hirnhäuten und machen rund 25 Prozent der Hirntumore aus. Sie können sich einzeln ausbilden oder auch mit mehreren Tumoren, sind üblicherweise scharf begrenzt, infiltrieren nicht das benachbarte Gewebe. Dadurch können die Veränderungen – 85 Prozent sind WHO-Grad I – meist gut operativ entfernt werden.
Allerdings gibt es auch atypische Meningeome. Sie machen rund zehn Prozent der Meningeome aus, wachsen bedeutend schneller und neigen eher zu Rezidiven. Eine hochmaligne Form stellen die anaplastischen Meningeome dar. Sie sind insgesamt relativ selten, bilden aber anders als viele andere Hirntumore auch Metastasen in anderen Organsystemen und haben eine ungünstige Prognose (WHO-Grad III).
Neurinome
Bei den Neurinomen handelt es sich meist um gutartige, langsam wachsende Prozesse, die sich im Schädelinneren und auch im Rückenmark bilden können. Besonders häufig unter den Neurinomen ist das Akustikusneurinom, eine Geschwulst des achten Hirnnervs, der auch der Hör- und Gleichgewichtsnervs ist.
Der Tumor ist meist im inneren Gehörgang lokalisiert und dehnt sich von dort in den so genannten Kleinhirnbrückenwinkel aus, eine kleine Nische unterhalb des Kleinhirns. Typische Symptome des Akustikusneurinoms sind Hörminderung, Schwindel und eventuell Lähmungserscheinungen im Gesicht, ein Tinnitus sowie Gleichgewichts-probleme und/oder eine gestörte Bewegungskoordination. Die malignen Strukturen werden entweder mittels Operation oder Radiotherapie behandelt.
Hypophysentumore
Zu den Hirntumoren gehören ferner die Hypophysentumore, die etwa 15 Prozent der Geschwülste im Gehirn ausmachen. Sie sind meist gutartig und wachsen von den Hormonzellen des Vorderlappens der Hirnanhangdrüse ausgehend in das umgebende Gewebe. Zu unterscheiden sind hormoninaktive und hormonaktive Hypophysentumore. Bei beiden Formen ist die Operation das Mittel der Wahl.
Lymphome des Gehirns
Eine Sonderstellung nehmen die Lymphome des Gehirns ein, da sie nicht von eigentlichen Hirnzellen abstammen. Sie leiten sich vielmehr von Immunzellen ab und bilden sich primär im Gehirn. Dies geschieht vor allem bei Patienten mit einer Immunschwäche, weshalb die Lymphome nicht selten bei älteren Menschen auftreten, bei Patienten nach einer Organtransplantation sowie bei Patienten mit HIV oder AIDS.
Da es sich nicht um solide Tumore handelt, ist eine Operation nicht möglich. Im Vordergrund steht vielmehr die Strahlentherapie, die mit einer Chemotherapie kombiniert werden kann.
Hirnmetastasen
Während Hirntumore selbst kaum zur Metastasierung neigen, können viele andere Krebsformen Metastasen im Gehirn absiedeln, wo sie dann als Tochtertumore heranwachsen. Hirnmetastasen machen nach Angaben der Deutschen Krebsgesellschaft bis zu 30 Prozent der Hirntumore aus. Vergleichsweise häufig treten sie auf beim Mammakarzinom sowie beim Bronchialkarzinom und beim malignen Melanom. Wenn die Diagnose gestellt wird, liegen meist sogar bereits mehrere Hirnmetastasen vor. Auch Hirnmetastasen werden, wenn möglich, operativ entfernt. Gegebenenfalls erfolgt anschließend eine Strahlenbehandlung.
Allgemeine Behandlung
Wie bereits erwähnt, steht bei der Therapie der Hirntumore die Operation an erster Stelle, wenn die Veränderungen gut zugänglich sind und sein Wachstum sowie ihr Ausmaß eine erfolgreiche Entfernung möglich erscheinen lassen. Häufig erfolgt zuvor eine Probeentnahme, und zwar computergesteuert mit stereotaktischer Technik, also minimalinvasiv.
Die offene Operation erfolgt meist ebenfalls computergestützt mit genauer Volumen-, Zielpunkt- und Zugangsberechnung sowie dreidimensionaler Rekonstruktion. Der Operateur erhält somit, so die Deutsche Krebsgesellschaft, genaue Informationen zur Lage des Tumors und das in direkter Beziehung zur knöchernen Struktur, zum Gehirn selbst und zu dessen funktionellen Arealen.
Besteht die Gefahr, dass die bösartige Struktur nicht vollständig entfernt wurde, so schließt sich eine Radiotherapie an, durch die verbliebene maligne Zellen am Wachstum gehindert oder sogar eliminiert werden sollen.
In den vergangenen Jahren wurden hochpräzise Bestrahlungstechniken entwickelt, so dass die Strahlentherapie mehr und mehr zu einer rein lokalen Maßnahme geworden ist.
Die dritte mögliche Behandlungsform ist die Chemotherapie, die ebenfalls darauf abzielt verbliebene Tumorzellen zu eliminieren. Es müssen dabei allerdings Zytostatika eingesetzt werden, die die Blut-Hirn-Schranke passieren können, die wichtigsten Substanzen sind Nitroso-Harnstoffe, Temozolomid und Procarbacin.
Warnsignale
Wie bei den meisten anderen Krebsformen, so gilt auch für viele Hirntumore, dass die Heilungschancen umso besser sind, je frühzeitiger das maligne Geschehen erkannt wird. Doch ähnlich wie andere maligne Prozesse, machen auch Hirntumore in ihren Frühstadien kaum Beschwerden. Treten eindeutige Symptome auf, so ist der Tumor oft aber schon erheblich heran gewachsen.
Treten solche Warnsignale auf, so sollten sie unbedingt Anlass sein, einen Neurologen aufzusuchen.
Diagnostisch lässt sich ein Hirntumor in aller Regel durch bildgebende Verfahren wie die Computertomographie sowie die Kernspintomographie bestätigen.
Christine VetterMerkenicher Str. 22450735 Köln